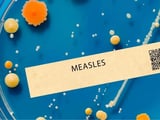

Measles Exposure Alert in Washtenaw County; Residents Urged to Monitor Symptoms and Get Vaccinated
March 11, 2026
A measles exposure event occurred in Washtenaw County, including Ypsilanti and Canton, with cases linked to several local locations from early March and residents advised to monitor for 21 days after exposure.
Exposure sites include Sidetrack Bar & Grill, T-Mobile in Ypsilanti, Cricket Wireless in Ellsworth, CVS Pharmacy on Michigan Avenue, plus local urgent care centers, with time windows for each location noted.
Symptoms to watch for include fever, cough, runny nose, red eyes, possible white mouth spots, and the characteristic red rash that begins on the face and spreads downward.
National influenza data show numerous pediatric deaths this season, underscoring concerns about vaccination gaps amid ongoing flu activity.
State health officials reiterate vaccination as the best protection against preventable diseases, noting elevated flu activity with hospitalizations and multiple outbreaks.
Unvaccinated individuals are at higher risk of illness after exposure, highlighting the importance of vaccination for prevention.
Washtenaw County Health Department offers vaccination clinics with walk-in hours and contact details for those seeking protection.
Public health guidance and vaccination information are available through the health department, with additional support channels such as local media for updates.
Vaccination recommendations are provided with an online link to Washtenaw County Health Department resources for more information.
Public health guidance advocates preventive measures like annual flu shots, COVID-19 and RSV vaccines as appropriate, plus handwashing and staying home when unwell to curb spread.
National context as of early March shows 1,281 confirmed measles cases nationwide, with Washtenaw County noting lower routine immunization coverage in some age groups.
The infected individual is isolated at home and vaccination is strongly encouraged for those not fully vaccinated.
Summary based on 11 sources
Get a daily email with more US News stories
Sources

CBS Detroit • Mar 11, 2026
Measles case reported in Washtenaw County, patient also had been in Wayne County
Patch • Mar 11, 2026
Measles Case Confirmed In Southeast MI: Officials List Exposure Sites
The Detroit News • Mar 11, 2026
Measles case confirmed in Washtenaw County
WDIV ClickOnDetroit • Mar 11, 2026
Measles case confirmed in Washtenaw County -- Here’s a list of exposure sites